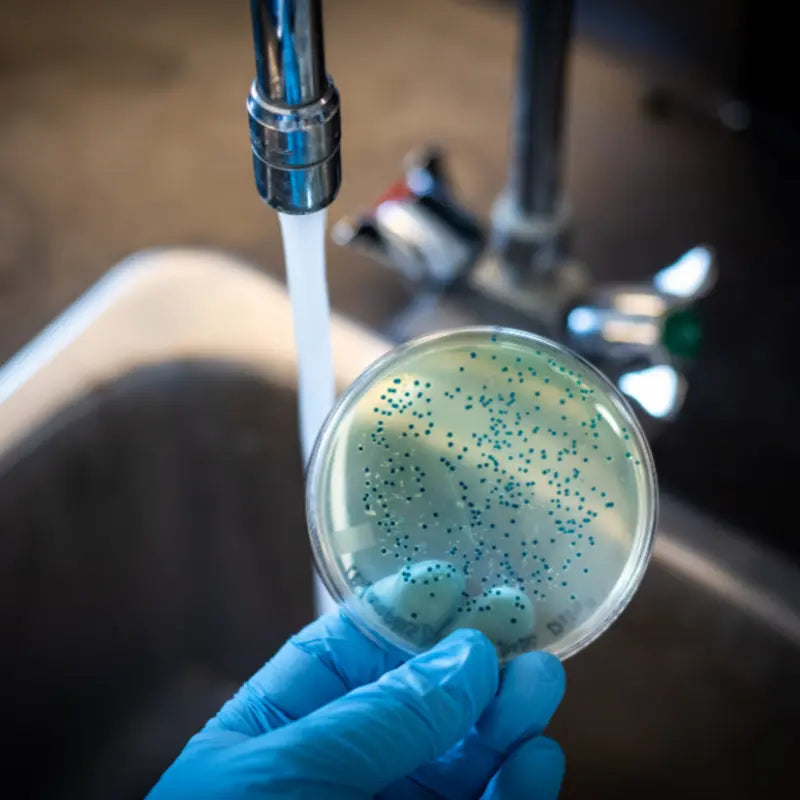

What Kills E Coli on Surfaces: How to Properly Sanitize Kitchen Surfaces
Did you know that nearly 1 in 6 Americans get sick from foodborne illnesses each year, with Escherichia coli (E. coli) being one of the most common culprits? Proper sanitation is crucial for preventing these illnesses, especially in the kitchen, where bacteria can easily thrive and contaminate food. This article will guide you through effective methods for sanitizing kitchen surfaces to ensure your cooking environment remains safe and healthy by eliminating coli bacteria.
Understanding Escherichia coli
Escherichia coli is a type of bacteria commonly found in the intestines of humans and animals. While most strains are harmless, some can lead to severe foodborne illnesses, known as coli infection. Sources of E. coli include undercooked ground beef, unpasteurized milk, and contaminated vegetables.
Coli outbreaks are often linked to food safety and health risks associated with E. coli bacteria. Infections can result in serious health risks, such as abdominal cramps, diarrhea, and vomiting, with symptoms appearing within days of exposure. Contaminated food, such as undercooked meat and unwashed produce, can lead to severe health risks. Kitchen surfaces can become a breeding ground for E. coli, especially when raw meats or unwashed produce come into contact with contaminated surfaces like countertops, cutting boards, and utensils. Therefore, understanding the risks associated with this bacteria is vital for foodborne illness prevention.
What is E Coli?

E. coli, or Escherichia coli, is a type of bacteria commonly found in the intestines of humans and animals. While most strains of E. coli are harmless, some can cause serious foodborne illnesses. These harmful strains can be found in contaminated food and water, and they can also spread through contact with infected individuals, making them highly contagious in close-contact settings. Understanding what E. coli is and how it spreads is crucial in preventing coli infections and outbreaks. By being aware of the sources and transmission methods of coli bacteria, you can take proactive steps to protect yourself and your family from contaminated food and water.
Symptoms of an E Coli Infection
Symptoms of an E. coli infection can vary depending on the location of the infection in the body. Common symptoms include watery diarrhea, stomach pain, and vomiting. In severe cases, E. coli infections can lead to life-threatening complications such as hemolytic uremic syndrome (HUS), which can cause kidney failure, and other serious conditions like thrombotic thrombocytopenic purpura (TTP), meningitis, septicemia, respiratory failure, and sepsis. Recognizing the symptoms of an E. coli infection is essential in seeking prompt medical attention and preventing long-term health consequences. If you experience any of these symptoms, especially after consuming potentially contaminated food, it is important to consult a healthcare professional immediately.
The Importance of Food Safety
Food safety is a critical aspect of maintaining public health, as it directly affects the well-being of individuals and communities. Harmful bacteria, such as E. coli, can contaminate food and cause severe illnesses, including urinary tract infections, respiratory infections, and even life-threatening conditions like hemolytic uremic syndrome. Therefore, it is essential to prioritize food safety practices, including proper handling, storage, and cooking of food, to prevent the spread of disease.
Deep Cleaning the Kitchen to Eliminate Harmful Bacteria

To maintain a hygienic environment, it’s essential to prioritize deep cleaning the kitchen regularly. Ideally, kitchens should undergo deep cleaning at least once a week. This involves a thorough scrub-down of all surfaces, particularly high-touch areas like handles, knobs, and countertops.
A checklist for deep cleaning could include the following steps:
-
Clear surfaces: Remove all items from countertops and tables.
-
Wipe down surfaces: Use warm, soapy water to clean all kitchen surfaces.
-
Sanitize: Apply a suitable sanitizer to kill remaining bacteria.
-
High-touch areas: Pay special attention to light switches, cabinet handles, and appliance surfaces.
Consider using effective disinfectants, such as hydrogen peroxide, to further reduce the risk of contamination.
Moreover, the proper disposal of waste is crucial to prevent bacteria growth. Use sealed bins for food waste, and dispose of waste regularly to minimize contamination risks.
Effective Cleaning Methods
When it comes to cleaning, using the right products can make a significant difference. Opt for safe cleaning products that are effective in eliminating bacteria and kill germs without posing health risks to your family. Many commercial disinfectants are available that can tackle E. coli effectively.
Another great option is cleaning with vinegar, which serves as a natural disinfectant. Mix equal parts of water and vinegar in a spray bottle to clean surfaces, including your cutting board. Not only is it safe, but it also eliminates bacteria and leaves a fresh scent.
Similarly, cleaning with baking soda can help scrub and deodorize surfaces. It’s excellent for removing stubborn stains and odors, making it an effective addition to your cleaning arsenal.
To ensure cleanliness, consider using bacteria testing kits. These kits allow you to monitor surface cleanliness and ensure your efforts are effective in eliminating harmful bacteria.
The Difference Between Cleaning and Sanitizing
Cleaning and sanitizing are two distinct steps in maintaining a hygienic environment, particularly in the kitchen. Cleaning involves physically removing dirt, grime, and some bacteria from surfaces using warm, soapy water. However, cleaning alone does not kill bacteria, and foodborne-illness causing bacteria can remain on surfaces for an extended period. Sanitizing, on the other hand, involves using a solution of 1 tablespoon of liquid chlorine bleach per gallon of water or a commercial sanitizer to kill bacteria and reduce the number of pathogens that survive in the kitchen. It is crucial to perform both cleaning and sanitizing steps to ensure a safe and healthy environment.
Effective Disinfection Methods
Effective disinfection methods are crucial in killing harmful bacteria, including E. coli, on contaminated surfaces. Some of the most effective methods include using hospital-grade disinfectants, which are designed to eliminate a wide range of pathogens. Cleaning and disinfecting surfaces and equipment regularly is also essential. Advanced systems like AeroClave can provide thorough disinfection for larger areas. Additionally, using hydrogen peroxide or bleach solutions can be highly effective in killing E. coli bacteria on surfaces. It’s essential to follow proper disinfection protocols, such as allowing the disinfectant to sit for the recommended contact time, to ensure the complete elimination of coli bacteria and prevent the spread of infection.
Best Practices for Safe Food Handling and Kitchen Hygiene
Maintaining a safe kitchen extends beyond cleaning surfaces. Proper hygiene practices are essential for minimizing contamination, especially when handling raw vegetables. Start with washing fruits and vegetables thoroughly under running water to remove any dirt or bacteria before cooking or eating.
Effective handwashing and sanitation practices are crucial for infection prevention, contributing to overall public health and disease control efforts.
Another important step is checking expiration dates regularly. This practice helps prevent the use of spoiled food, which can harbor harmful bacteria, including E. coli. Undercooked meat is a significant transmission route for E. coli, so ensure meat is cooked to the appropriate temperature to avoid foodborne illnesses.
Implementing kitchen organization tips can also reduce the risk of cross-contamination. Keep raw meats separate from ready-to-eat foods in the refrigerator and designate specific cutting boards for different food types to maintain a safe cooking environment.
Handling Raw Meat Safely
Handling raw meat requires extra caution to prevent the spread of harmful bacteria like E. coli. When handling raw meat, it is essential to:
-
Wash hands thoroughly with soap and running water before and after handling raw meat
-
Use separate cutting boards and utensils for raw meat to prevent cross-contamination
-
Store raw meat in sealed containers at the bottom of the refrigerator to prevent juices from dripping onto other foods
-
Cook raw meat to the recommended internal temperature to kill bacteria
By following these guidelines, individuals can significantly reduce the risk of coli infections and maintain a safe food handling environment.
Why Sanitize Kitchen Surfaces?
Sanitizing kitchen surfaces is essential in preventing the spread of foodborne illnesses, including E. coli infections. Kitchen surfaces, such as cutting boards, countertops, and sinks, can harbor harmful bacteria, including E. coli, which can contaminate food and cause infection. By regularly sanitizing these surfaces, you can kill harmful bacteria and reduce the risk of coli infections. This practice is crucial for maintaining food safety and preventing the spread of disease. Ensuring that your kitchen surfaces are clean and sanitized can help protect you and your family from the dangers of contaminated food.
Common Areas to Sanitize
High-Touch Areas
High-touch areas in the kitchen, such as faucets, appliance handles, and countertops, are common areas where E. coli bacteria can spread. These areas require frequent sanitizing to prevent the spread of infection. Additionally, cutting boards, utensils, and dishes should also be sanitized regularly, especially after handling raw meat, poultry, or produce. Sanitizing these high-touch areas can help reduce the risk of coli infections and maintain food safety. By paying attention to these critical areas, you can create a safer cooking environment and minimize the risk of harmful bacteria contaminating your food.
Milerd Detoxer: An Innovative Solution for Food Safety

The Milerd Detoxer is a state-of-the-art device designed to elevate food safety standards by effectively eliminating harmful bacteria, such as E. coli, from your food. Utilizing advanced detoxification technology, this product ensures that fruits, vegetables, and other foods are thoroughly cleansed and safe for consumption. Incorporating the Milerd Detoxer into your daily kitchen routine can significantly minimize the risk of coli infections and other foodborne illnesses. Its intuitive design and efficient operation make it an indispensable tool for anyone dedicated to ensuring a healthy and safe cooking environment. For more information on how the Milerd Detoxer can transform your food safety practices, visit Milerd Detoxer.
Regular Maintenance and Monitoring for Food Safety
A daily cleaning routine can go a long way in keeping your kitchen safe from bacteria. Focus on regularly cleaning countertops, cutting boards, and utensils to maintain hygiene.
It's equally important to monitor for signs of contamination, such as unusual odors or spills, and respond promptly. Utilizing the Milerd Detoxer can enhance your sanitation efforts, ensuring kitchen surfaces remain free from harmful bacteria.
Conclusion
In conclusion, preventing Escherichia coli in your kitchen involves a comprehensive approach to sanitation, incorporating effective cleaning techniques, strict hygiene practices, and regular monitoring. While these measures are essential, the optimal solution for ensuring the highest level of food safety is the Milerd Detoxer. This advanced device efficiently eliminates harmful bacteria, providing an unparalleled level of cleanliness and safety for your cooking environment. By integrating the Milerd Detoxer into your daily routine, you can transform your kitchen into a haven of health and security for you and your family. Start today to ensure your kitchen remains a safe and healthy space!

Lasă un comentariu
Acest site este protejat de hCaptcha și hCaptcha. Se aplică Politica de confidențialitate și Condițiile de furnizare a serviciului.